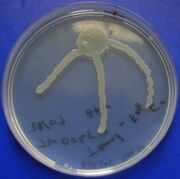

Uploads by James Wu
From OpenWetWare
Jump to navigationJump to search
This special page shows all uploaded files.
| Date | Name | Thumbnail | Size | Description |
|---|---|---|---|---|
| 15:03, 26 October 2008 | Cambridge Voltage Glu Response.jpg (file) |  |
1.66 MB | Glutamate Response |
| 16:32, 1 August 2008 | Cambridge Logo.gif (file) | 3 KB | ||
| 15:35, 1 August 2008 | Dmtry and Kath.tiff (file) |  |
46 KB | |
| 23:27, 31 July 2008 | Mutant Plate 2.jpg (file) | |
15 KB | |
| 23:21, 31 July 2008 | Mutant Plate 3.jpg (file) |  |
16 KB | |
| 23:14, 31 July 2008 | Mutants Plate.jpg (file) |  |
19 KB | |
| 23:14, 31 July 2008 | Mutant Plate.jpg (file) |  |
15 KB | |
| 22:55, 31 July 2008 | 1st Gel OsmY KDP PCR.jpg (file) |  |
14 KB | |
| 22:47, 31 July 2008 | Piko PCR.jpg (file) |  |
15 KB | |
| 22:33, 31 July 2008 | Chris and Flame Photometer.jpg (file) |  |
36 KB | Chris posing with the Flame Photometer*'''~~~~''': |
| 16:22, 24 July 2008 | Kathryn.jpg (file) |  |
23 KB |